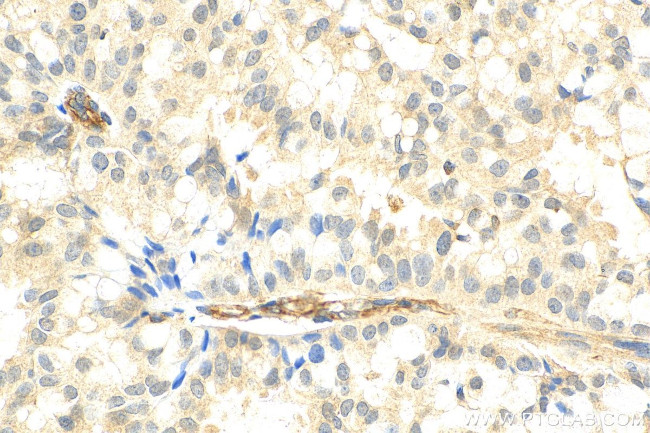
PCID2 Antibody in Immunohistochemistry (Paraffin) (IHC (P))

Search
Proteintech
PCID2 Polyclonal Antibody
{{$productOrderCtrl.translations['antibody.pdp.commerceCard.promotion.promotions']}}
{{$productOrderCtrl.translations['antibody.pdp.commerceCard.promotion.viewpromo']}}
{{$productOrderCtrl.translations['antibody.pdp.commerceCard.promotion.promocode']}}: {{promo.promoCode}} {{promo.promoTitle}} {{promo.promoDescription}}. {{$productOrderCtrl.translations['antibody.pdp.commerceCard.promotion.learnmore']}}
产品信息
26638-1-AP150UL
种属反应
宿主/亚型
分类
类型
偶联物
形式
浓度
规格
纯化类型
保存液
内含物
保存条件
运输条件
靶标信息
Required for B-cell survival through the regulation of the expression of cell-cycle checkpoint MAD2L1 protein during B cell differentiation. Component of the TREX-2 complex (transcription and export complex 2), composed of at least ENY2, GANP, PCID2, DSS1, and either centrin CETN2 or CETN3 (PubMed:22307388). The TREX-2 complex functions in docking export-competent ribonucleoprotein particles (mRNPs) to the nuclear entrance of the nuclear pore complex (nuclear basket). TREX-2 participates in mRNA export and accurate chromatin positioning in the nucleus by tethering genes to the nuclear periphery. Binds and stabilizes BRCA2 and is thus involved in the control of R-loop-associated DNA damage and transcription-associated genomic instability. R-loop accumulation does not increase in PCID2-depleted cells.
仅用于科研。不用于诊断过程。未经明确授权不得转售。
篇参考文献 (0)
生物信息学
蛋白别名: CSN12-like protein; PCI domain-containing protein 2; RP11-98F14.6; unnamed protein product
基因别名: F10; HT004; PCID2
UniProt ID: (Human) Q5JVF3
Entrez Gene ID: (Human) 55795